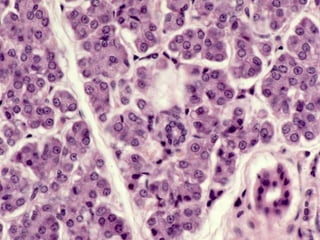

Incrustar presentación
Descargado 33 veces
























































































































































Este documento presenta imágenes microscópicas de diferentes tipos de tejidos y estructuras celulares teñidas con varios métodos histológicos. Incluye fotografías que muestran fibras de colágeno, elásticas y reticulares en diversos órganos, así como membranas basales y células especializadas de órganos como riñones, glándulas mamarias y próstata. El propósito es demostrar la aplicación de técnicas histológicas para visualizar componentes celulares y tej